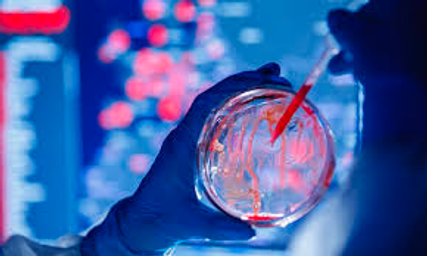

Data science solutions: Domino’s enterprise MLOps platform
Scale data science with Domino
Our customers have proven that it doesn’t matter how many data scientists you have, what data science tools you use, or the type of infrastructure you run on. When you add Domino you can scale data science.
With Domino’s Enterprise MLOps platform you get:
Data science productivity
Domino supports the broadest ecosystem of infrastructure and tools in the market. Data scientists can use their favorite tools without having to worry about how to configure them. No matter where your data lives, you can make it available for projects. IT can consolidate siloed technology stacks onto a single governed data science platform running on-prem or in the cloud while also supporting distributed compute networks such as Spark, Ray, and Dask. No more bespoke laptops! Instead, you have a future-proofed platform with no vendor lock-in.
Collaboration and re-use
Capture and share collective wisdom from all corners of your business to turbocharge data scientist productivity. With Domino, you capture and track all project artifacts including code, package versions, and parameters to establish full visibility, repeatability, and reproducibility at any time across the end-to-end data science lifecycle. This means you never will lose valuable IP when data scientists change jobs and new team members can become productive faster.
Governance and standardization
Centralize and orchestrate all data science work on one platform with enterprise-grade security, governance, compliance, and policies to scale safely and universally across your organization.
Model velocity
Accelerate innovation by removing friction from every aspect of the data science lifecycle. End-to-end workflows create common patterns and practices used by everyone regardless of their role or favored data science tool so you can get more models into production, faster.